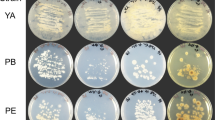

Abstract
A screening of soil samples for d-amino acid oxidase (d-AAO) activity led to the isolation and identification of the gram-positive bacterium Arthrobacter protophormiae. After purification of the wild-type d-AAO, the gene sequence was determined and designated dao. An alignment of the deduced primary structure with eukaryotic d-AAOs and d-aspartate oxidases showed that the d-AAO from A. protophormiae contains five of six conserved regions; the C-terminal type 1 peroxisomal targeting signal that is typical for d-AAOs from eukaryotic origin is missing. The dao gene was cloned and expressed in Escherichia coli. The purified recombinant d-AAO had a specific activity of 180 U mg protein−1 for d-methionine and was slightly inhibited in the presence of l-methionine. Mainly, basic and hydrophobic d-amino acids were oxidized by the strictly enantioselective enzyme. After a high cell density fermentation, 2.29 × 106 U of d-AAO were obtained from 15 l of fermentation broth.
Similar content being viewed by others
Avoid common mistakes on your manuscript.
Introduction
d-Amino acid oxidases (d-AAOs, EC 1.4.3.3) constitute a well-investigated group of flavoenzymes that are known since Krebs 1935. They catalyze the oxidative deamination of d-amino acids to the corresponding keto acids, produce ammonia and hydrogen peroxide as by-products and contain flavin adenine dinucleotide (FAD) as non-covalently bound cofactor. d-AAOs from fungi, fish, birds, reptiles and different mammalian tissues have been discovered during the last decades (Konno and Yasumura 1992). The best explored d-AAOs originate from pig kidney (Curti et al. 1973; Fukui et al. 1987; Watanabe et al. 1989) and the yeasts Rhodotorula gracilis (Alonso et al. 1998; Casalin et al. 1991; Harris et al. 1999; Molla et al. 1998; Pilone et al. 1989a; Pilone et al. 1987; Ramon et al. 1998) and Trigonopsis variabilis (Berg and Rodden 1976; Gonzalez et al. 1997; Isoai et al. 2002; Szwajcer and Mosbach 1985; Yu et al. 2002). The crystal structures of the d-AAOs from R. gracilis and pig kidney were resolved (Mattevi et al. 1996; Miura et al. 1997; Umhau et al. 2000), and different approaches of enzyme engineering were performed to better understand their catalytic, structural and biotechnological properties (Boselli et al. 2004; Caldinelli et al. 2006; Ju et al. 2000; Piubelli et al. 2002; Sacchi et al. 2002).
Most of the characterized d-AAOs oxidize hydrophobic, neutral and basic d-amino acids, whereas d-glutamic acid and d-aspartic acid are not accepted as substrates. These substances were oxidized by a functional related group of enzymes, the d-aspartate oxidases (d-AspO, EC 1.4.3.1), that oxidize solely acidic d-amino acids (Negri et al. 1987; Simonic et al. 1997). d-AAOs from yeasts are involved in the metabolic utilization of d-amino acids, whereas the physiological function of mammalian d-AAOs is still uncertain. Recently, it was demonstrated that d-AAO regulates the N-methyl-d-aspartate receptor-mediated neurotransmission in the brain by degrading d-serine (Mothet et al. 2000).
d-AAOs are of special biotechnological interest, as some enzymes of this group catalyze the first step in large-scale processes that lead to 7-amino cephalosporanic acid, a precursor of semisynthetic cephalosporins (Pilone and Pollegioni 2002; Pollegioni et al. 2004; Tishkov and Khoronenkova 2005). In combination with hydride reducing agents, d-AAOs were also applied for the cyclic deracemization and stereoinversion of α-amino acids (Beard and Turner 2002).
Basic local alignment search tool (BLAST) searches reveal various sequences from bacteria that show similarities to known eukaryotic d-AAOs, but no functional bacterial d-AAO has been described so far. In this paper, we report on the purification, overexpression and biochemical characterization of a highly active d-AAO from the environmental isolate Arthrobacter protophormiae.
Materials and methods
Media and growth conditions
Different dilutions of soil suspensions were prepared in 0.9% NaCl solution and plated on mineral agar medium containing 0.2 g l−1 of sodium propionate as sole carbon source and 0.01 g l−1 of potassium nitrate as sole nitrogen source (Goodfellow and Minnikin 1981). Strains were isolated by transferring colonies to M65 medium (10 g of malt extract, 4 g of glucose and 4 g of yeast extract per liter) that was solidified by the addition of 1.5% (w/v) agar. Single colonies were subsequently inoculated in M65 broth and grown at 30°C. The crude extracts of the cells and the culture supernatants were separately tested for d-AAO activity.
One soil isolate that exhibited d-AAO activity was assigned to the species A. protophormiae by the Deutsche Sammlung von Mikroorganismen und Zellkulturen (DSM 15035). The strain was grown aerobically in M65 broth supplemented with 2.7 g of l-alanine per liter (pH 7.2). After 24–28 h of cultivation at 30°C, the cells were harvested by centrifugation and stored at −20°C.
Purification of d-AAO from A. protophormiae and Escherichia coli BL21(DE3) carrying pE1D
Fifty grams of A. protophormiae cells were suspended in 10 mM potassium phosphate buffer (pH 7.0) and disrupted in a glass bead mill (SCP-Disintegrator, Innomed-Konsult AG, Sweden) as described previously (Geueke and Hummel 2002). The crude extract was loaded onto a Q-Sepharose FF column (2.6 by 10 cm; GE Healthcare) that was equilibrated with 10 mM potassium phosphate buffer (pH 7.0). The flow rate was 2 ml min−1. The column was washed with 10 mM potassium phosphate buffer (pH 7.0) containing 0.2 M NaCl and the d-AAO eluted at a concentration of 0.35 M sodium chloride. Active fractions were pooled and loaded onto a column that was packed with ceramic MacroPrep hydroxyapatite, type I (1.6 by 8.3 cm; BioRad). The column was equilibrated with 150 mM KCl in 10 mM potassium phosphate buffer (pH 6.8) and operated at a flow rate of 2 ml min−1. The d-AAO activity was detected in the flow through. The active fractions were dialyzed against 50 mM triethanolamine (TEA)–HCl buffer containing 20% PEG 20000 (PEG, polyethylene glycol; pH 7.0). The concentrated sample was loaded onto a preparative, native polyacrylamide gel (10%) using the 491 Prep Cell (BioRad) and eluted with 50 mM TEA–HCl buffer (pH 7.0).
Escherichia coli BL21(DE3) carrying the plasmid pE1D was cultivated aerobically in 100-ml shaking flasks containing 20-ml Luria-Bertani (LB) medium supplemented with 100 μg ampicillin ml−1. The cells were incubated at 37°C and 200 rpm and induced with 0.1 mM isopropyl-β-d-thiogalactopyranoside (IPTG) at an optical density of OD550 0.5. After induction, the temperature was reduced to 30°C. Escherichia coli BL21(DE3) carrying pE1D was disrupted by ultrasonification. The recombinant d-AAO was purified using anion exchange and hydroxyapatite chromatography as described for the wild-type enzyme.
N-terminal sequencing
The N-terminal sequence of the d-AAO was determined on an Automated Sequencer 477A with a 12A PTH analyser (Applied Biosystems). Partially purified d-AAO was separated by sodium dodecyl sulfate-polyacrylamide gel electrophoresis (SDS-PAGE) and digested with the endoproteinase Lys-C. The digest, separation by high-performance liquid chromatography (HPLC) and sequencing of one internal peptide was carried out by Toplab (Martinsried, Germany).
PCR conditions
All PCR reactions were performed using the Taq polymerase (Qiagen) with the supplied buffer. Two degenerated primers were constructed for the partial amplification of the dao gene from genomic DNA (P8for 5′-cgsatcaccgtsatcggctccggcgtsat-3′ and P10rev 5′-cttgtgytgsagsacytcsaggccytcsag-3′). The amplification procedure consisted of 3 min at 95°C followed by 8 cycles of 40 s at 95°C, 1 min at 72–64°C, 1 min at 72°C and 25 cycles of 40 s at 95°C, 1 min at 68°C and 1 min at 72°C. The reaction was stopped after a final incubation step for 10 min at 72°C. DNA sequencing was carried out by Sequiserve (Vaterstetten, Germany).
Identification and cloning of the dao gene
The dao gene sequence was isolated with the Universal GenomeWalker™ Kit (BD Clontech; http://www.clontech.com/products/literature/pdf/brochures/GenomeWalker.pdf). Genomic DNA was cut with NruI, EcoRV, PvuII, StuI, NaeI and FspI (BD Clontech or New England Biolabs). The GenomeWalker adaptors were ligated to the genomic DNA fragments, and these libraries were used as templates in nested PCR reactions with the following primers: Apfor3 5′-gcaccaggtcaccgtcgcctacgacca-3′, Aprev3 5′-caccagcttggcagcgcgttccagga-3′, Apfor4 5′-cgccgccgccatctggttcccgtacca-3′, Aprev4 5′-ctgcggttcgacttcgcggttccagtcgtt-3′. The amplification procedures consisted of 3 min at 94°C followed by 4 cycles of 1 min at 94°C, 30 s at 65°C, 3 min at 72°C, 30 cycles of 1 min at 94°C, 30 s at 62°C and 3 min at 72°C. The reaction was stopped after a final incubation step for 10 min at 72°C.
The restriction sites NdeI and BamHI were attached to the dao gene by PCR to allow cloning into the expression plasmid pET21a (EMD Biosciences). Genomic DNA from A. protophormiae was used as a template, and the following primers were applied: ApNdeIfor 5′-ggaattccatatgcccacagcaccgttgag-3′ and ApBamHIrev 5′-cgggatccctagctggccggctcgcca-3′. The PCR product and pET21a were digested with NdeI and BamHI, purified, ligated and transformed into E. coli BL21(DE3). Clones were tested by restriction digest and sequencing of the newly obtained plasmid pE1D.
High cell density fermentation of E. coli BL21(DE3) carrying pE1D
A fed-batch fermentation was carried out using the following medium for the batch (per liter): 0.2 g of NH4Cl, 2 g of (NH4)2SO4, 13 g of KH2PO4, 10 g of K2HPO4, 6 g of NaH2PO4·H2O, 3 g of yeast extract, 2 g of glucose, 0.1 g of ampicillin, 9.3 mg of Na2EDTA·2H2O, 0.1 g of thiamine, 0.3 ml of antifoam, 5 ml of vitamin and 4 ml of trace element solution. The feed medium consisted of 0.2 g of NH4Cl, 2 g of (NH4)2SO4, 13 g of KH2PO4, 10 g of K2HPO4, 6 g of NaH2PO4, 21 g of yeast extract, 600 g of glucose, 10 g of MgSO4·7H2O, 0.4 ml of antifoam, 5 ml of vitamin and 2 ml of trace element solution per liter. The vitamin solution contained (per liter): 0.1 g of riboflavin, 10 g of thiamine/HCl, 0.5 g of nicotinic acid, 0.5 g of pyridoxine/HCl, 0.5 g of Ca-panthotenate, 1 mg of biotin, 2 mg of folic acid and 10 mg of cyanocobalamin. The trace element solution contained (per liter): 10 g of CaCl2·H2O, 0.5 g of ZnSO4·7H2O, 0.25 g of CuCl2·2H2O, 2.5 g of MnSO4·H2O, 1.75 g of CoCl2·6H2O, 0.125 g of H3BO3, 2.5 g of AlCl3·6H2O, 0.5 g of Na2MoO4·2H2O, 10 g of FeSO4·7H2O.
The fermenter was inoculated by adding 1% (v/v) of preculture grown in LB medium containing 100 μg of ampicillin ml−1. The cultivation was carried out in a Techfors fermenter using the IRIS software (Infors, Bottmingen, Switzerland). The batch volume was 10 l and the feed volume 5 l. For the fed-batch fermentation, an exponential feeding strategy according to Korz et al. (1995) was slightly modified and applied according to the following equation:
m S is the mass flow of substrate (g h−1), y X/S is the biomass/substrate yield coefficient (g g−1), m is the specific maintenance coefficient (g g−1 h−1), X is the biomass concentration (g l−1) and V is the cultivation volume (l). The constant specific growth rate μ set was set to 0.12 h−1. The cells were induced with 0.5 mM IPTG after 28 h of cultivation. The pO2 was adjusted to 30% by adapting the stirrer speed, the pressure and the aeration rate. The pH was maintained at 7 by adding NH4OH, and the temperature was kept at 30°C. The cells were harvested with a separator KA06 (Westfalia, Oelde, Germany) after a total fermentation time of 39 h.
Analytical methods
The d-AAO activity was measured spectrophotometrically at 30°C and 436 nm following the oxidation of o-dianisidine by hydrogen peroxide that was catalyzed by an excess of peroxidase (ɛ = 8.1 mM−1 cm−1). Unless otherwise stated, 1 ml of assay mixture contained 10 mM d-methionine, 0.2 M TEA–HCl buffer (pH 7.6), 0.2 mg of o-dianisidine, 100 U peroxidase and d-AAO in limiting amounts. One U was defined as the amount of enzyme that catalyzes the degradation of 1 μmol d-amino acid per minute. The K m for the d-AAO was determined at 30°C with d-methionine concentrations in the range of 0.2–10 mM. The influence of l-methionine on the d-AAO activity was measured in the presence of 90 mM l-methionine and 1 to 20 mM d-methionine. The kinetic data were fitted with the MicroMath Scientist software (Saint Louis, USA).
Protein concentration was determined according to Bradford with bovine serum albumin as a standard. The purity and expression rates of d-AAO samples were monitored by polyacrylamide gel electrophoresis using Bis/Tris-gels (4–12%) and the NuPAGE-System (Invitrogen). The native molecular weight of the purified enzyme was determined by gel filtration with a Superdex 200 PG column as published previously (Geueke and Hummel 2002). Isoelectric focussing was performed using precast Serva polyacrylamide gels with a narrow pH range (pH 4–6).
Accession number
The nucleotide sequence of the dao gene was submitted to the GenBank under accession no. AY306197.
Results
Screening for d-AAO activity
A selective screening of 99 soil samples was performed to isolate bacteria that belong to the genera Rhodococcus and Nocardia and have l-amino acid oxidase activity (Geueke and Hummel 2002). Four of the isolated strains exhibited d-AAO activity, whereas only one isolate oxidized l-amino acids. The strain with the highest activity toward the d-amino acids d-phenylalanine, d-leucine and d-methionine was a gram-positive, non-motile and strict aerobic bacterium. Analysis of the 16S rDNA gene sequence showed that the organism belongs to the species A. protophormiae (DSM15035). Under the reported growth conditions, a specific activity of 0.003 U mg protein−1 was reached in the crude extract of the wild-type strain with d-methionine as substrate. Different d- and l-amino acids were added to the medium and tested as possible inducers, but no increase in the activity could be observed (data not shown). As the attempt to raise the d-AAO expression rate in the wild type to a biotechnologically interesting level did not seem to be promising, we decided to identify the dao gene.
Purification of the d-AAO and identification of the dao gene sequence
The d-AAO was purified from 50 g of A. protophormiae cells using two chromatographical steps followed by dialysis and preparative native gel electrophoresis. The enzyme was partially inactivated during the purification procedure. The N-terminal sequence of the d-AAO was determined by automated Edman degradation (PTALPRITVIGSGVIGLSAA). The N-terminal methionine seemed to be processed. After proteolytic digestion with endoproteinase Lys-C and separation of the peptides by HPLC, one internal peptide was also sequenced (LVPELEGLEVLEHK). Degenerated primers were designed on the basis of this sequence information and used for PCR. A fragment of 700 bp was amplified and identified as part of the dao gene. The application of the Universal GenomeWalker™ Kit led to a DNA fragment of 1,933 bp that was completely sequenced by primer walking. The dao open reading frame is coding for a protein of 326 amino acids corresponding to a theoretical molecular mass of 34.6 kDa per monomer. The start codon ATG is preceded by a potential ribosome binding site (aaagga).
A BLAST search revealed that the d-AAO from A. protophormiae showed high similarities to hypothetical proteins from Mycobacterium leprae (CAC30966), Streptomyces coelicolor (T35265), Anopheles gambiae (EAA01013) and Caenorhabditis elegans (T19979) and to d-AspO from human (AAH32786) or bovine (P31228) origin (Fig. 1).
Alignment of d-AAO from A. protophormiae (AAP70489), four hypothetical d-AspOs and two mammalian d-AspO. The sequence identities of the d-AAO from A. protophormiae to the putative d-AspOs as well as the mammalian d-AspOs and the corresponding accession numbers are as follows: 33%—Mycobacterium leprae (CAC30966), 37%—Streptomyces coelicolor (T35265), 35%—Anopheles gambiae (EAA01013), 32%—Caenorhabditis elegans (T19979), 29%—human d-AspO (AAH32786), 31%—bovine d-AspO (P31228). The alignment was generated with the ClustalW algorithm. Identical amino acids are marked black, residues with high similarity dark gray and with low similarity light gray. Regions I and III and regions II, IV and V are involved in coenzyme and substrate binding, respectively. All eukaryotic proteins have the C-terminal type 1 peroxisomal targeting signal S(K/N)L (marked by a frame)
Heterologous expression of the dao gene
The dao gene was cloned into the multiple cloning site of the expression plasmid pET21a yielding pE1D that was subsequently transformed into E. coli BL21(DE3). Experiments in shaking flasks were performed to optimize the expression conditions by varying the induction temperature (25, 30, 37°C), the IPTG concentration (0.01–1 mM) and the induction time (2–6 h). Best results were obtained when the cells were induced with 0.1 mM IPTG at an optical density of 0.5 followed by 4 h of incubation at 30°C. Under these conditions, the maximal specific d-AAO activity in the crude extract reached 30 U mg protein−1.
Different concentrations of FAD (0–15 μM) were added to the assay mixture to measure if the enzyme was partially expressed as apoenzyme and if it could be reconstituted by the addition of cofactor. The activity in the crude extracts was not increased when external FAD was added.
Production and purification of recombinant d-AAO
After the high cell density fermentation, 1.9 kg of cells (wet weight) that had an activity of 1,200 U g cells−1 (wet weight) was harvested. The specific activity in the crude extract was 15 U mg protein−1. We obtained 2.29 × 106 U of d-AAO from one 15-l fermentation.
The recombinant d-AAO was isolated to homogeneity using a two-step procedure (Table 1). The specific activity of 30 U mg protein−1 in the crude extract could be increased sixfold to 180 U mg protein−1 after the second chromatography. We obtained 1,434 U of d-AAO from 3 g of cells (wet weight) that corresponded to a yield of 56%. The purification process was monitored by polyacrylamide gel electrophoresis (Fig. 2).
Polyacrylamide gel electrophoresis of d-AAO containing samples at different stages of purification from E. coli BL21(DE3)/pE1D, corresponding to Table 1. Lane M marker; lane 1 crude cell extract; lane 2 pool after anion exchange chromatography; lane 3 pool after hydroxyapatite chromatography
Structural and biochemical characterization
The d-AAO had a native molecular mass of 69 kDa as measured by gel filtration. In combination with the experimentally and theoretically determined molecular mass of the monomer, this result clearly indicated that the enzyme formed a homodimer. The isoelectric point was 4.4 as determined by isoelectric focussing.
The d-AAO showed activity mainly against basic and hydrophobic d-amino acids (Table 2). Small uncharged and acidic d-amino acids as well as cephalosporin C were not, or only weakly, oxidized. The enzyme exhibited an absolute stereoselectivity for the tested d-enantiomers. The K m for d-methionine was 1.0 ± 0.1 mM, whereas l-methionine was a weak, noncompetitive inhibitor for the d-AAO (K i=315 ± 39 mM) when d-methionine was used as substrate. No further l-amino acids were tested as inhibitors. The purified enzyme had a specific activity of 180 U mg protein−1 for d-methionine. The d-AAO had a pH optimum between 6.5 and 8.5, and it was stable at pH values between 6 and 9. The enzyme did not loose activity at temperatures up to 30°C for at least 2 h; it had a half life of 21 min at 40°C and of 2 min at 50°C when it was incubated in 100 mM TEA–HCl buffer (pH 7.6).
Discussion
The d-AAO from A. protophormiae is, to our knowledge, the first characterized enzyme of this class that originates from a bacterial source. The discovery of this prokaryotic d-AAO was facilitated by screening microbial isolates from soil applying a coupled o-dianisidine/peroxidase assay. The high stability and sensibility of oxidized o-dianisidine (Gabler et al. 2000) allowed the detection of very low enzyme amounts in the crude extract of A. protophormiae. One reason for the, hitherto, lack of information on prokaryotic d-AAOs might be the low expression rate in the wild-type strains as we observed in this study. A comparison of the specific d-AAO activities in the crude extract of A. protophormiae (0.003 U mg protein−1) with recombinant cells (15–30 U mg protein−1) showed that the enzyme was expressed at extremely low amounts in the wild type. The expression rates of the fungal d-AAO-producing strains R. gracilis and T. variabilis were 0.6 U mg protein−1 (Pilone et al. 1989b) and up to 233 U g cell dry weight−1 (Gabler and Fischer 1999; Hörner et al. 1996; Umhau et al. 2000), respectively. These d-AAO activities were induced in the presence of N-carbamoyl-d-alanine, d-alanine or d-3-aminobutyric acid.
After the high cell density fermentation of E. coli BL21(DE3)/pE1D, we obtained 153,000 U l fermentation broth−1. This value is at least 20-fold higher than all activities that were published for the expression of recombinant and wild-type d-AAOs (Yu et al. 2002; Zheng et al. 2006). Also the specific activity in the crude extracts of recombinant cells (15–30 U mg protein−1) exceeds the published data for yeast d-AAOs by factors between 3.4 and 60 (Yu et al. 2002; Zheng et al. 2006).
Addition of FAD to the crude extract of E. coli BL21(DE3)/pE1D and to the purified d-AAO did not increase the activity of the enzyme, indicating that it might be completely expressed as holoenzyme with a very low dissociation constant of FAD. It is also conceivable that it was partially expressed as apoenzyme, but could not bind the added FAD. This behavior differs from other d-AAOs that were expressed in E. coli. Up to 62% of the R. gracilisd-AAO were expressed as apoenzyme in E. coli (Alonso et al. 1998), and the activity of recombinant T. variabilis d-AAO could be increased by 33% when FAD was added to the enzyme assay (Lin et al. 2000).
Under the specified conditions, purified d-AAO from A. protophormiae exhibits a specific activity of 180 U mg protein−1 for d-methionine. Comparing the activities of d-AAOs from different sources shows that the bacterial enzyme belongs to the highly active d-AAOs. The T. variabilis d-AAO had a specific activity of 86 U mg protein−1 for d-alanine (30°C, 50 mM sodium pyrophosphate, pH 8.5; Pollegioni et al. 1993). Depending on the purification scheme, the R. gracilisd-AAO reached specific activities of 58–175 U mg protein−1 for d-alanine, when the activity was measured at 37°C in 75 mM sodium pyrophosphate, pH 8.5 (Pilone et al. 1989a; Pilone et al. 1987). The d-AAOs from the yeasts T. variabilis, R. gracilis and C. boidinii, as well as the fungal and mammalian enzymes from Fusarium oxysporum and pig kidney, respectively, also oxidize d-methionine with high activities.
The purified recombinant d-AAO has a dimeric structure like the enzymes from the well-known yeast strains and an isoelectric point of 4.4, which is lower than the pIs measured for the d-AAOs from R. gracilis (7.8/7.4/7.2), porcine kidney (7.0/7.2) and T. variabilis (5.1) (Pilone et al. 1989a; Pollegioni et al. 1993). The A. protophormiae d-AAO has high sequence similarities to putative d-AAOs from different sources and two mammalian d-AspOs (Fig. 1). Several conserved stretches were identified according to Faotto et al. (1995) (Fig. 1). Regions I and III are part of the coenzyme binding site; regions II, IV and V contain residues that are involved in substrate binding and form the active site. The published primary structures of eukaryotic d-AAOs and d-AspO contain a C-terminal signal sequence (SKL) that directs the protein to the peroxisomes (organelles that contain enzymes mainly catalyzing oxidative reactions) and is missing in the shown prokaryotic sequences. The localization of mammalian and yeast d-AAOs in the peroxisomes was proven for several species.
The results described here show that the spectrum of biotechnologically useful d-AAOs was broadened by this highly active and biochemically interesting enzyme from A. protophormiae.
References
Alonso J, Barredo JL, Diez B, Mellado E, Salto F, Garcia JL, Cortes E (1998) d-amino-acid oxidase gene from Rhodotorula gracilis (Rhodosporidium toruloides) ATCC 26217. Microbiology 144:1095–1101
Beard TM, Turner NJ (2002) Deracemization and stereoinversion of α-amino acids using d-amino acid oxidase and hydride reducing agents. Chem Commun 3:246–247
Berg CP, Rodden FA (1976) Purification of d-amino oxidase from Trigonopsis variabilis. Anal Biochem 71:214–222
Boselli A, Piubelli L, Molla G, Sacchi S, Pilone MS, Ghisla S, Pollegioni L (2004) On the mechanism of Rhodotorula gracilis d-amino acid oxidase: role of the active site serine 335. Biochim Biophys Actia 1702:19–32
Caldinelli L, Molla G, Pilone MS, Pollegioni L (2006) Tryptophan 243 affects interprotein contacts, cofactor binding and stability in d-amino acid oxidase from Rhodotorula gracilis. FEBS J 273:504–512
Casalin P, Pollegioni L, Curti B, Pilone Simonetta M (1991) A study on apoenzyme from Rhodotorula gracilisd-amino acid oxidase. Eur J Biochem 197:513–517
Curti B, Ronchi S, Branzoli U, Ferri G, Williams CH (1973) Improved purification, amino acid analysis and molecular weight of homogenous d-amino acid oxidase from pig kidney. Biochim Biophys Acta 327:266–273
Faotto L, Pollegioni L, Ceciliani F, Ronchi S, Pilone MS (1995) The primary structure of d-amino acid oxidase from Rhodotorula gracilis. Biotechnol Lett 17:193–198
Fukui K, Watanabe F, Shibata T, Miyake Y (1987) Molecular cloning and sequence analysis of cDNAs encoding porcine kidney d-amino acid oxidase. Biochemistry 26:3612–3618
Gabler M, Fischer L (1999) Production of a new d-amino acid oxidase from the fungus Fusarium oxysporum. Appl Environ Microbiol 65:3750–3753
Gabler M, Hensel M, Fischer L (2000) Detection and substrate selectivity of new microbial d-amino acid oxidases. Enzyme Microb Technol 27:605–611
Geueke B, Hummel W (2002) A new bacterial l-amino acid oxidase with a broad substrate specificity: purification and characterization. Enzyme Microb Technol 31:77–87
Gonzalez FJ, Montes J, Martin F, Lopez MC, Ferminam E, Catalan J, Galan MA, Dominguez A (1997) Molecular cloning of TvDAO1, a gene encoding a d-amino acid oxidase from Trigonopsis variabilis and its expression in Saccharomyces cerevisiae and Kluyveromyces lactis. Yeast 13:1399–1408
Goodfellow M, Minnikin DE (1981) The genera Nocardia and Rhodococcus. In: Starr MP, Stolp H, Trüper HG, Balows A, Schlegel HG (eds) The prokaryotes, 1st edn. Springer, Berlin Heidelberg New York, pp 2016–2027
Harris CM, Molla G, Pilone MS, Pollegioni L (1999) Studies on the reaction mechanism of Rhodotorula gracilisd-amino-acid oxidase. Role of the highly conserved Tyr-223 on substrate binding and catalysis. J Biol Chem 274:36233–36240
Hörner R, Wagner F, Fischer L (1996) Induction of the d-amino acid oxidase from Trigonopsis variabilis. Appl Environ Microbiol 62:2106–2110
Isoai A, Kimura H, Reichert A, Schorgendorfer K, Nikaido K, Tohda H, Giga-Hama Y, Mutoh N, Kumagai H (2002) Production of d-amino acid oxidase (DAO) of Trigonopsis variabilis in Schizosaccharomyces pombe and the characterization of biocatalysts prepared with recombinant cells. Biotechnol Bioeng 80:22–32
Ju SS, Lin LL, Chien HR, Hsu WH (2000) Substitution of the critical methionine residues in Trigonopsis variabilisd-amino acid oxidase with leucine enhances its resistance to hydrogen peroxide. FEMS Microbiol Lett 186:215–219
Konno R, Yasumura Y (1992) d-amino-acid oxidase and its physiological function. Int J Biochem 24:519–524
Korz DJ, Rinas U, Hellmuth K, Sanders EA, Deckwer WD (1995) Simple fed-batch technique for high cell density cultivation of Escherichia coli. J Biotechnol 39:59–65
Krebs HA (1935) Metabolism of amino acids. Deamination of amino acids. Biochem J 29:77–93
Lin LL, Chien HR, Wang WC, Hwang TS, Fu HM, Hsu WH (2000) Expression of Trigonopsis variabilisd-amino acid oxidase gene in Escherichia coli and characterization of its inactive mutants. Enzyme Microb Technol 27:482–491
Mattevi A, Vanoni MA, Todone F, Rizzi M, Teplyakov A, Coda A, Bolognesi M, Curti B (1996) Crystal structure of d-amino acid oxidase: a case of active site mirror-image convergent evolution with flavocytochrome b2. Proc Natl Acad Sci USA 93:7496–7501
Miura R, Setoyama C, Nishina Y, Shiga K, Mizutani H, Miyahara I, Hirotsu K (1997) Structural and mechanistic studies on d-amino acid oxidase × substrate complex: implications of the crystal structure of enzyme × substrate analog complex. J Biochem (Tokyo) 122:825–833
Molla G, Vegezzi C, Pilone MS, Pollegioni L (1998) Overexpression in Escherichia coli of a recombinant chimeric Rhodotorula gracilisd-amino acid oxidase. Protein Expr Purif 14:289–294
Mothet JP, Parent AT, Wolosker H, Brady Jr RO, Linden DJ, Ferris CD, Rogawski MA, Snyder SH (2000) d-Serine is an endogenous ligand for the glycine site of the N-methyl-d-aspartate receptor. Proc Natl Acad Sci USA 97:4926–4931
Negri A, Massey V, Williams CH Jr (1987) d-aspartate oxidase from beef kidney. Purification and properties. J Biol Chem 262:10026–10034
Pilone MS, Pollegioni L (2002) d-Amino acid oxidase as an industrial biocatalyst. Biocatal Biotransform 20:145–159
Pilone SM, Vanoni A, Casalin P (1987) Purification and properties of d-amino acid oxidase, an inducible flavoenzyme from Rhodotorula gracilis. Biochim Biophys Acta 914:136–142
Pilone SM, Pollegioni L, Casalin P, Curti B, Ronchi S (1989a) Properties of d-amino-acid oxidase from Rhodotorula gracilis. Eur J Biochem 180:199–204
Pilone SM, Verga R, Fretta A, Hanozet GH (1989b) Induction of d-amino acid oxidase by d-alanine in Rhodotorula gracilis grown in defined medium. J Gen Microbiol 135:593–600
Piubelli L, Caldinelli L, Molla G, Pilone MS, Pollegioni L (2002) Conversion of the dimeric d-amino acid oxidase from Rhodotorula gracilis to a monomeric form. A rational mutagenesis approach. FEBS Lett 526:43–48
Pollegioni L, Buto S, Tischer W, Ghisla S, Pilone MS (1993) Characterization of d-amino acid oxidase from Trigonopsis variabilis. Biochem Mol Biol Int 31:709–717
Pollegioni L, Caldinelli L, Molla G, Sacchi S, Pilone MS (2004) Catalytic properties of d-amino acid oxidase in cephalosporin C bioconversion: a comparison between proteins from different sources. Biotechnol Prog 20:467–473
Ramon F, Castillon M, De La Mata I, Acebal C (1998) Chemical mechanism of d-amino acid oxidase from Rhodotorula gracilis: pH dependence of kinetic parameters. Biochem J 330:311–314
Sacchi S, Lorenzi S, Molla G, Pilone MS, Rossetti C, Pollegioni L (2002) Engineering the substrate specificity of d-amino acid oxidase. J Biol Chem 277:27510–27516
Simonic T, Duga S, Negri A, Tedeschi G, Malcovati M, Tenchini ML, Ronchi S (1997) cDNA cloning and expression of the flavoprotein d-aspartate oxidase from bovine kidney cortex. Biochem J 322:729–735
Szwajcer E, Mosbach K (1985) Isolation and partial characterization of a d-amino acid oxidase against cephalosporin C from the yeast Trigonopsis variabilis. Biotechnol Lett 7:1–7
Tishkov VI, Khoronenkova SV (2005) d-Amino acid oxidase: structure, catalytic mechanism, and practical application. Biochemistry (Mosc) 70:40–54
Umhau S, Pollegioni L, Molla G, Diederichs K, Welte W, Pilone MS, Ghisla S (2000) The X-ray structure of d-amino acid oxidase at very high resolution identifies the chemical mechanism of flavin-dependent substrate dehydrogenation. Proc Natl Acad Sci USA 97:12463–12468
Watanabe F, Fukui K, Momoi K, Miyake Y (1989) Expression of normal and abnormal porcine kidney d-amino acid oxidase in Escherichia coli: purification and characterization of the enzymes. Biochem Biophys Res Commun 165:1422–1427
Yu J, Li D-Y, Zhang Y-J, Yang S, Li R, Yuan Z-Y (2002) High expression of Trigonopsis variabilisd-amino acid oxidase in Pichia pastoris. J Mol Catal B Enzym 18:291–297
Zheng H, Wang X, Chen J, Zhu K, Zhao Y, Yang Y, Yang S, Jiang W (2006) Expression, purification, and immobilization of His-tagged d-amino acid oxidase of Trigonopsis variabilis in Pichia pastoris. Appl Microbiol Biotechnol 70:683–689
Acknowledgment
This project was financially supported by the Degussa AG and the Deutsche Bundesstiftung Umwelt (Förderschwerpunkt Biotechnologie, ICBio, Az 13094). We thank Truc Pham for technical assistance and Holger Gieren for expert help with the fermentation.
Author information
Authors and Affiliations
Corresponding author
Rights and permissions
About this article
Cite this article
Geueke, B., Weckbecker, A. & Hummel, W. Overproduction and characterization of a recombinant D-amino acid oxidase from Arthrobacter protophormiae . Appl Microbiol Biotechnol 74, 1240–1247 (2007). https://doi.org/10.1007/s00253-006-0776-9
Received:
Revised:
Accepted:
Published:
Issue Date:
DOI: https://doi.org/10.1007/s00253-006-0776-9